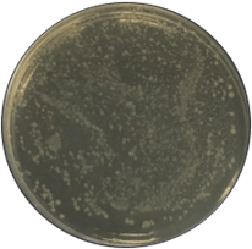
図：歯周病菌（ジンジバリス菌）に対する抗菌活性の実験結果 L8020乳酸菌SD末添加なし

L8020乳酸菌
健全なヒトの口から発見された
ヒト由来の乳酸菌。
商品ラインアップ
-

L8020乳酸菌SD末
L8020乳酸菌の特徴
-
特徴1
ヒト由来の乳酸菌
ヒトの口の中には、300~700種類の細菌が生息していると言われています。しかし、ヒトによって健全な口の状態を保てるのはどうしてでしょう?それは、口の中の善玉菌が悪玉菌の増殖を抑えているから。
その健全な口の人から得られた善玉菌がL8020乳酸菌です。
-
特徴2
菌の生育を抑制
L8020乳酸菌は、抗菌物質を分泌していると言われています。そのため、その抗菌物質が、歯周病菌や虫歯菌の増殖を抑制し高い死滅率を示します。

-
特徴3
高い熱安定性
抗菌活性は高い熱安定性を示し、120℃、10分間加熱しても抗菌活性は失われません。また、L8020乳酸菌SD末は、死菌体であることから、あらゆる食品工場でも扱うことができ、加工食品における加熱殺菌でも安定した抗菌活性を示します。

L8020乳酸菌SD末の抗菌活性
歯周病菌(ジンジバリス菌)に対する
抗菌活性
L8020乳酸菌SD末
添加なし
[2.5×103cells/plate]

L8020乳酸菌SD末
添加あり
(25㎎/ml)
[0 cell/plate]
歯周病菌の生育を抑制!!
オーラルケアの重要性

-
口腔機能の衰えは
身体・精神的フレイルのはじまり高齢者の身体・精神・社会的な虚弱を意味する「フレイル」という言葉が大きな注目を集めています。中でも口腔機能の衰えである「オーラルフレイル」は身体・精神的フレイルのはじまりとされています。
-
口の中の歯周病菌が
全身疾患を引き起こす口の中の歯周病菌は唾液や血液で運ばれて全身疾患を引き起こします。
-
若いうちからの対策が重要
健康長寿を全うするためには、虫歯や口臭、歯周病のない健康な口腔維持が必要であり、それは若いうちからの対策が重要です。

健康はオーラルケアから
L8020乳酸菌SD末の用途
日常の食品からオーラルケアを可能に!

- □幼児から高齢者までのオーラルケアに
- □独自製法により加工しやすい粉末化
- □死菌であるため、熱にも安定し
あらゆる食品工場で加工可能

備前化成は
L8020協議会に参加しています
商品ラインアップ
-

L8020乳酸菌SD末




















